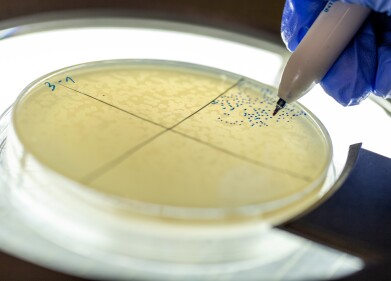

-
.jpg) Pictured Left to right: Lana Amosova (Aston University, KTP Operations Manager); Emma Begley (KTP Associate); Catrina Milgate (Alpharmaxim: Director of Editorial and Scientific Services); Susan Suttle (Innovate UK Business Connect: KT Adviser); Dr Jason Thomas (Aston University: Senior Lecturer in Psychology); Will Hind (Alpharmaxim CEO) and Dr Carl Senior (Aston University, Reader in Psychology)
Pictured Left to right: Lana Amosova (Aston University, KTP Operations Manager); Emma Begley (KTP Associate); Catrina Milgate (Alpharmaxim: Director of Editorial and Scientific Services); Susan Suttle (Innovate UK Business Connect: KT Adviser); Dr Jason Thomas (Aston University: Senior Lecturer in Psychology); Will Hind (Alpharmaxim CEO) and Dr Carl Senior (Aston University, Reader in Psychology) -

Research news
KTP initiative supports changing perceptions of new drug adoption
Sep 30 2024
Behavioural science experts from Aston University’s School of Psychology have been working with healthcare communications agency Alpharmaxim to develop a method for transforming attitudes and beliefs about how best to treat rare and complex diseases like Parkinson’s.
The Healthcare Behaviour Insights Tool (H-BIT) supported through a Knowledge Transfer Partnership (KTP) and based on a validated behaviour change framework, is the world’s first model that can determine common key barriers to behaviour change in a given disease area across Europe.
While new pharmaceuticals can take many years to develop, prescribing physicians’ reluctance to adopt them also remains a significant challenge, whether due to a range of deep-seated beliefs about preferred approaches to treatment or outdated prescribing habits. Drug-launch campaigns often fall short of informing new attitudes and beliefs because of limited insights about what drives clinical decision-making across different countries and cultures.
H-BIT now equips Alpharmaxim to work with clients to target a range of complex and rare diseases where there is growing recognition of the need to change prescribing behaviours. Initially designed around approaches to Parkinson’s, the company has also created a library of commercially available guides about the common barriers that behaviour change campaigns need to overcome when launching a new drug.
This new knowledge could also inform smarter, evidence-based communications campaigns with the potential to improve disease management for patients across Europe. Will Hind, Founder and CEO at Alpharmaxim, said: “Aston University’s expertise from the forefront of behavioural science and the team’s ability to drive this project through to an end point has given us statistically relevant data and a proprietary model that is ready to deploy commercially. Their unique understanding of how to apply robust qualitative methods and complex statistical tools has been vital to the project’s success.”
Dr Carl Senior, Reader in Psychology from the School of Psychology at Aston University, commented: “The opportunity to consolidate our methods into a coherent model for driving behaviour change in the field of medical communications is an academic achievement that would not have been possible without an industry partnership with Alpharmaxim. The University’s innovation ecosystem, which brings together a range of expert disciplines across one institution, was a key factor in our ability to deliver this work.”
More information online
Digital Edition
Lab Asia Dec 2025
December 2025
Chromatography Articles- Cutting-edge sample preparation tools help laboratories to stay ahead of the curveMass Spectrometry & Spectroscopy Articles- Unlocking the complexity of metabolomics: Pushi...
View all digital editions
Events
Jan 21 2026 Tokyo, Japan
Jan 28 2026 Tokyo, Japan
Jan 29 2026 New Delhi, India
Feb 07 2026 Boston, MA, USA
Asia Pharma Expo/Asia Lab Expo
Feb 12 2026 Dhaka, Bangladesh